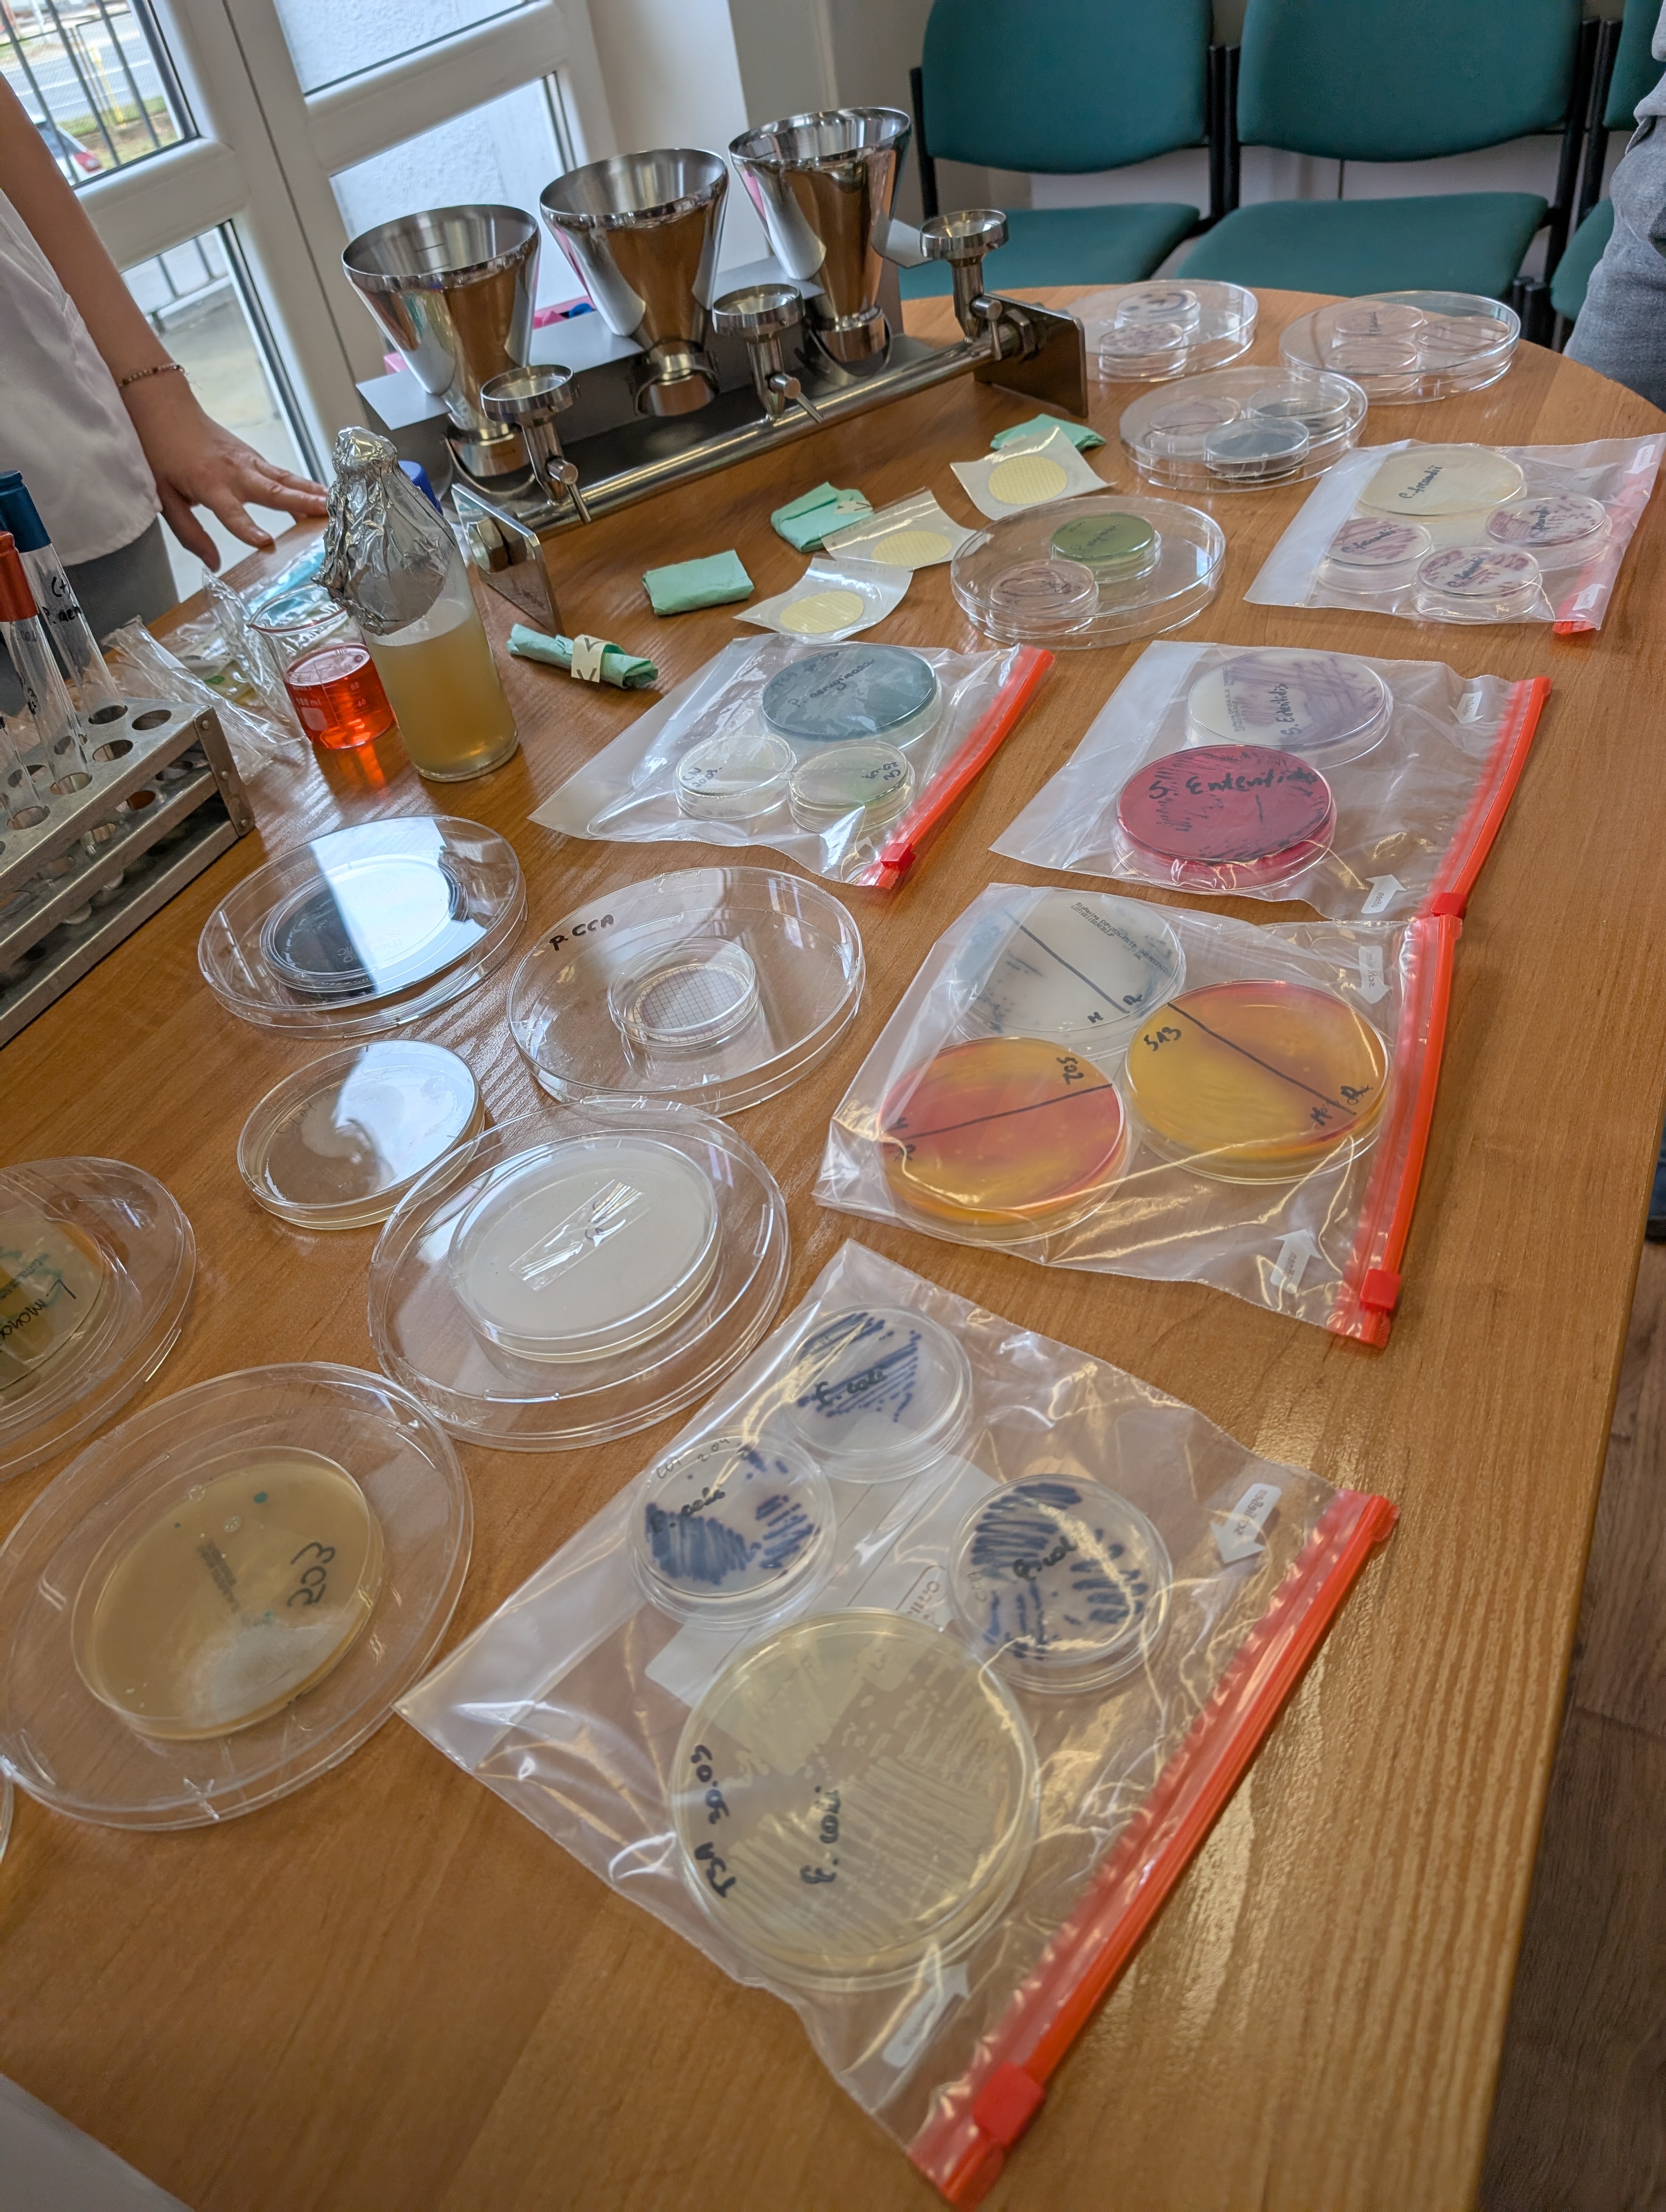

Dzień otwarty w Laboratorium
10.04.2026
10.04.2026 roku w Oddziale Laboratoryjnym Powiatowej Stacji Sanitarno-Epidemiologicznej w Jeleniej Górze odbyło się wyjątkowe spotkanie w ramach Dni Otwartych, dedykowane dla młodzieży.

10.04.2026 roku w Oddziale Laboratoryjnym Powiatowej Stacji Sanitarno-Epidemiologicznej w Jeleniej Górze odbyło się wyjątkowe spotkanie w ramach Dni Otwartych, dedykowane dla młodzieży.
Uczniowie szkół ponapodstawowych mogli zapoznać się z działalnością porwadzoną przez Oddział Laboratoryjny oraz Sekcję Poboru Próbek i Orzecznictwa Powiatowej Stacji Sanitarno-Epidemiologicznej w Jeleniej Górze.
Uczestnicy dzisiejszego wydarzenia mogli poznać pracę laboratorium od środka. Pracownicy PSSE w Jeleniej Górze zorganizowali sześć różnych punktów tematycznych opisujących pracę poniższych laboratoriów.:
- Laboratorium Badania Powietrza i Szkodliwości Fizycznych
- Laboratorium Mikrobiologii Klinicznej
- Laboratorium Analiz Instrumentalnych
- Laboratorium Badań Fizykochemicznych
- Laboratorium Badań Mikrobiologicznych
- Sekcja Poboru Próbek i Orzecznictwa